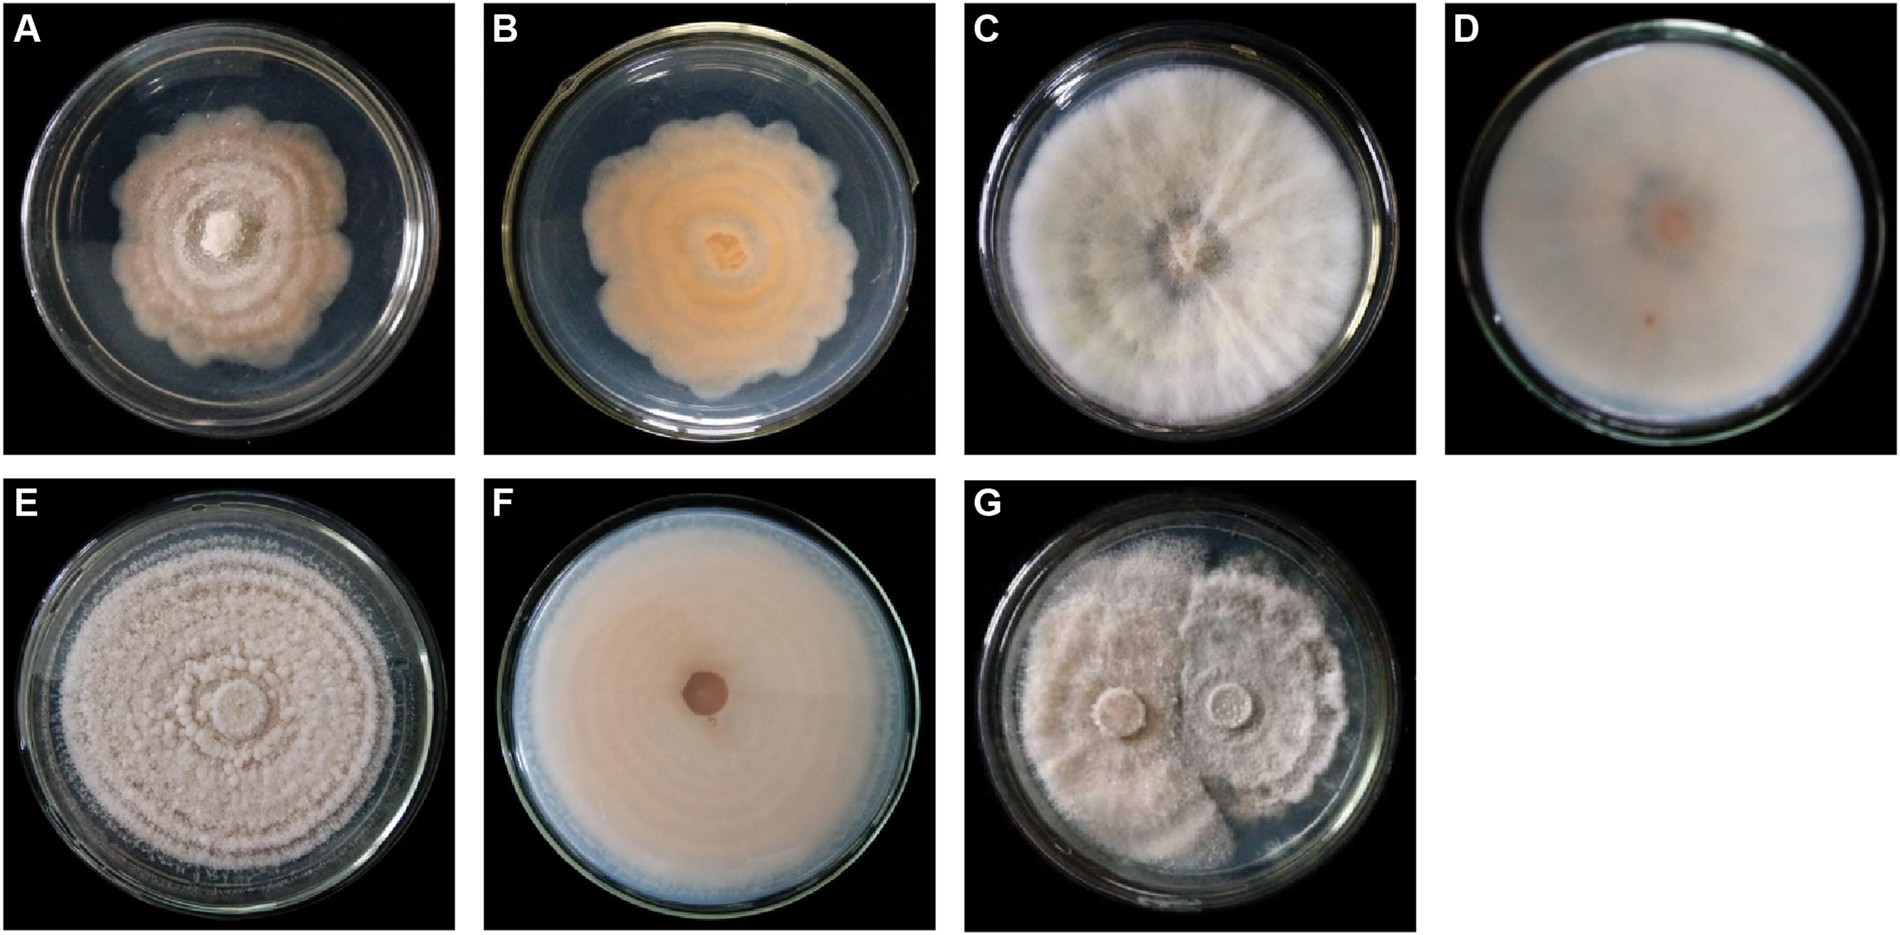
Figure 5

Figure 5
From: Inhibitory effect and mechanism of Tagetes erecta L. fungicide on Fusarium oxysporum f. sp. niveum
Colony morphology of FON and FONM. Positive (A) and negative (B) side of FON on PDA solid medium. Positive (C) and negative (D) side of FONM on PDA solid medium. Positive (E) and negative side of FONM on 0.8 mg/mL TEF on PDA solid medium. (G) Plate confrontation test between FON (right) and FONM (left) on PDA solid medium.